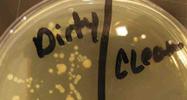

| ||||
Use of Liquid Nutrient Broth Media for Growing Bacteria - P2
Other Factors That Influence Bacterial Growth in Broth
In addition to oxygen requirements, there are other factors that can influence microbial growth patterns in liquid. Motile bacteria (those with flagella) can swim. Their movement will create a uniform cloudiness (turbidity) in the broth. Non-motile bacteria with waxy cell walls tend to float at the surface of the broth, producing a surface membrane called a pellicle.
Other types of non-motile bacteria sink to the bottom of the tube, forming sediment. Some of these bacteria tend to stick together in clumps called flocculent growth.
Page last updated: 3/2016
SPO VIRTUAL CLASSROOMS
PAGE 2 < Back to Page 1
Liquid growth media swirled to show "tornado" of flocculant bacterial growth.
When bacteria grow dispersed in liquid, colony morphology cannot be assessed. Still information can be had from how bacteria grow in liquid media. See photos below.
Want to see more photos? > Bacterial Media Images
Sources & Resources
- Bacterial Growth Media & Culture Laboratory Exercise Main Page from the Virtual Microbiology Classroom.
- Leboffe, M. J. and Pierce, B. E. (2010) Microbiology Laboratory Theory and Application, Third Edition. Morton Publishing Company.
- Bauman, R. (2014) Microbiology With Diseases by Taxonomy, 4th ed. Pearson Benjamin Cummings.
- Park Talaro, K. (2008) Foundations in Microbiology. McGraw Hill
Left photo: Bacillus subtilis produces flocculent (flaky, clumped) growth in liquid media; Right photo: Mycobacterium smegmatis growing on the surface of the media, forming a pellicle (film on the surface of the media and and interior of the test tube, a biofilm at the liquid / air interface).
Left photo: Lactococcus lactis grows as a sediment at the bottom of the tube; Right photo: Staphylococcus epidermidis growing in liquid media creates a turbid, cloudy broth.
End of Article
Disadvantages of Using Liquid Bacterial Growth Media
Although there are many advantages to growing bacteria in broth, one of the main disadvantages is that bacterial colonies do not form in a liquid suspension. A colony is a collection of bacteria that have arisen from the division of a single parent bacterium, meaning that all bacteria in a colony are the same type.
Being able to view colonies can help researchers see if a growth medium has been contaminated with another type of unwanted bacteria, since, in some cases, the colony of contaminant bacteria will look different than the majority of colonies present.
TSY touch plates with bacterial growth
from fingertips.
 | ||||
SPO HOME SCIENCE PROJECT
Does Your Automatic Dishwasher Kill All The Prokaryotes Living On Your Dirty Dishes?
Click here to find out!
SCIENCE PHOTOS
You have free access to a large collection of materials used in two college-level introductory microbiology courses (8-week & 16-week). The Virtual Microbiology Classroom provides a wide range of free educational resources including PowerPoint Lectures, Study Guides, Review Questions and Practice Test Questions.